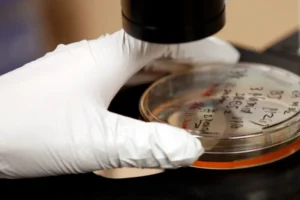
A bactéria que pode causar milhões de casos de câncer

SÃO PAULO, SP (FOLHAPRESS) – O Hezbollah propôs uma trégua de uma semana a Israel a partir das 0h desta quinta-feira (16, 18h em Brasília). A medida, anunciada pela TV ligada ao grupo fundamentalista xiita libanês Al-Mayadeen, será analisada pelo gabinete de Binyamin Netanyahu, segundo a mídia israelense.
Mantendo a tradição de negociar com pressão, o governo israelense disse que irá manter suas posições no sul do Líbano, o qual vem desocupando para criar uma zona tampão de sua fronteira até o rio Litani, que fica a uma distância máxima de 30 km do território israelense.
A região, disse o ministro Israel Katz (Defesa), é uma “zona da morte” para o Hezbollah, que historicamente ataca o norte israelense a partir de cidades e posições montanhosas por lá. O grupo já foi o mais poderoso preposto do Irã no Oriente Médio, mas está enfraquecido.
Segundo a Al-Mayadeen, a trégua foi informada por Teerã, que busca esticar o prazo de seu próprio cessar-fogo com os Estados Unidos -que lançaram uma guerra ao lado de Israel contra o Irã em 28 de fevereiro. O Hezbollah não chegou a divulgar comunicado.
Os combates cessaram na semana passada, mas o prazo dado por Donald Trump para um acordo acaba na próxima terça (21). O Irã recebeu uma delegação liderada por Asim Munir, chefe militar do Paquistão, país que sediou a primeira e inconclusa rodada de negociações com os EUA, para enviar nova proposta de conversa com os americanos.
Segundo a agência Bloomberg, Teerã quer adiar em pelo menos duas semanas o fim da trégua. Na mesa estão itens espinhosos, como a manutenção de sua capacidade de produzir urânio enriquecido, que os EUA querem ver suspensa para evitar o risco de uma bomba atômica, e a livre navegação no estreito de Hormuz, ora obstruída por um duplo bloqueio iraniano-americano.
Já Netanyahu não incluiu o Hezbollah, grupo fundado em 1982 na esteira da ocupação do Líbano por Israel que durou até 2000, no cessar-fogo. Os fundamentalistas atacaram o Estado judeu logo depois do início da guerra atual.
Tel Aviv promoveu uma ação dupla. Primeiro, lançou os mais duros ataques contra o vizinho logo depois da trégua com o Irã, matando mais de 300 das cerca de 2.000 pessoas morta no conflito até aqui em um só dia.
Segundo, abriu negociações diretas com o Líbano pela primeira vez desde 1993, mas excluindo o Hezbollah. Na quarta (14) houve a primeira rodada de conversas, com mediação dos EUA, em Washington.
É um caminho acidentado. Os fundamentalistas se opuseram às conversas entre os governos, cientes de que elas miram seu desarmamento. Só que o Hezbollah é ainda a força militar mais eficaz do Líbano, além de participar da política institucional como um partido no Parlamento.
Mais cedo, nesta quarta, o deputado do Hezbollah Hassan Fadlallah afirmou que as negociações sem o grupo seriam destinadas ao fracasso e o Líbano, a mais uma guerra civil como a que destroçou o país de 1975 a 1990. A proposta de trégua anunciada à tarde mostra que talvez ele só estivesse falando grosso.
Por outro lado, nada indica disposição dos militantes em depor armas. Eles já vinham enfraquecidos de sua guerra em 2024 com Israel, resultado do apoio que deram aos terroristas palestinos do Hamas após o ataque ao Estado judeu de 7 de outubro do ano anterior.
Nesta quarta, os combates continuaram, com ao menos nove mortos no Líbano e ao menos 30 foguetes e drones lançados contra Israel.
Uma leitura possível de uma eventual trégua é que, além da pressão iraniana, o Hezbollah está tentando salvar suas capacidades militares. Isso não parece estar no rol de termos aceitáveis para Netanyahu, que vê a oportunidade de acabar com a ameaça na sua fronteira norte um prêmio de guerra ainda maior do que o conflito com o Irã.
Com isso, o contestado premiê poderia ter um trunfo para as eleições parlamentares de outubro. Se as perder, Netanyahu corre o risco de ir para a cadeia devido ao processo em que é investigado sob suspeita de corrupção. Trump, seu aliado, até agora falhou em obter um perdão presidencial em Israel para o político.
Para o Líbano, é uma oportunidade única, ainda que em meio à tragédia de ter visto a maior perda de moradores em proporção populacional neste conflito -foram 3.500 ataques ao Hezbollah por Israel até aqui, enquanto o grupo se manteve como a principal força retaliatória contra o rival.
Tanto o presidente quanto o primeiro-ministro do país querem ver o Hezbollah submetido, mas não têm musculatura militar para tal.
A ocupação já anunciada do sul libanês por Israel, nesse cenário, seria uma moeda de troca simbólica para Netanyahu: ele deixaria a região quando houvesse alguma certeza de que o Hezbollah não irá mais a usar para atacar o Estado judeu.
O problema é evidente: os fundamentalistas podem resistir ao processo e o país cair num conflito doméstico, ou ainda aceitar formalmente o desarmamento, mas buscar uma forma de se reequipar para o futuro.
Leia Também: Avião passa 2 horas voando em círculos antes de cair na Bolívia

Adicionar Comentário